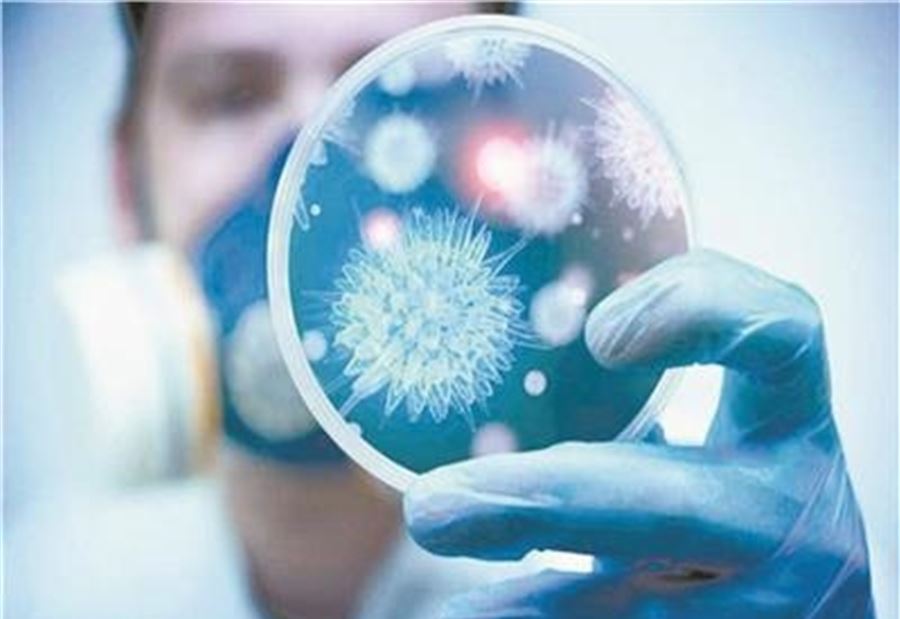

يوصي خبراء الصحة بـ "ارتداء الكمامات لأجل كبح تفشي فيروس كورونا المستجد"، مع التأكيد على أنّ "درجة الوقاية تختلفُ من كمامة إلى أخرى، وبحسب المادة التي صنعت منها".
ونقلت صحيفة "غارديان" البريطانية عن دراسة يابانية، أن "الكمامات غير المنسوجة تحقّق حماية أكبر ضد فيروس كورونا".
وأضافت: "المقصود بالكمامات غير المنسوجة هو الكمامات القابلة للارتداء مرة واحدة فقط، وهي مألوفة في العادة لدى الجراحين، وتتخذ اللون الأزرق الفاتح".
وتتمّ صناعة هذه الكمامات من مادة "البولي بروبيلين" وهي "الأرخص في السوق مقارنة بباقي الكمامات الأخرى".
وتابع المصدر أن "هذه الكمامات أكثر قدرة على وقف انتشار جزيئات الرذاذ الصغيرة المنبعثة من عملية التنفس".
وأوصت منظمة الصحة العالمية، بـ "غسل كمامات القطن والبولستير القابلة لإعادة الاستخدام وتنظيفها مرة واحدة على الأقل بالصابون والماء في حرارة لا تقل عن 60 درجة مئوية".
ويذكر أن "باحثين أكدوا أن الكمامات غير المنسوجة عرقلت تدفق الرذاذ بأكمله"، بينما كانت الكمامات الأخرى "أقل نجاعة، لكنها تمكنت من كبح 80% من القطرات".
تــابــــع كــل الأخــبـــــار.
إشترك بقناتنا على واتساب

Follow: Lebanon Debate News

الـــمــــزيــــــــــد
الـــمــــزيــــــــــد





